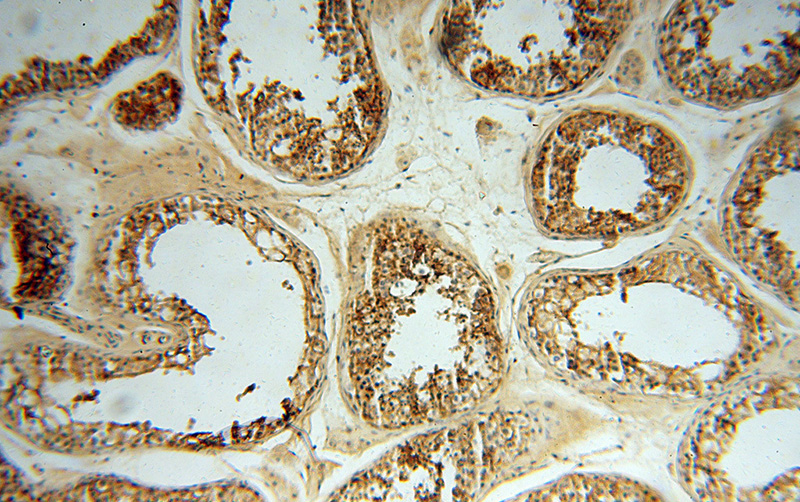
Immunohistochemical of paraffin-embedded human testis using Catalog No:109087(SLC3A2 antibody) at dilution of 1:100 (under 10x lens)

-
Product Name
CD98 antibody
- Documents
-
Description
CD98 Rabbit Polyclonal antibody. Positive WB detected in HeLa cells. Positive IF detected in HepG2 cells. Positive IHC detected in human testis tissue, human placenta tissue. Positive FC detected in HepG2 cells. Observed molecular weight by Western-blot: 85 kDa,120 kDa
-
Tested applications
ELISA, WB, IHC, IF, FC
-
Species reactivity
Human; other species not tested.
-
Alternative names
4F2 antibody; 4F2 heavy chain antigen antibody; 4F2HC antibody; 4T2HC antibody; CD98 antibody; CD98HC antibody; MDU1 antibody; NACAE antibody; SLC3A2 antibody
-
Isotype
Rabbit IgG
-
Preparation
This antibody was obtained by immunization of CD98 recombinant protein (Accession Number: NM_002394). Purification method: Antigen affinity purified.
-
Clonality
Polyclonal
-
Formulation
PBS with 0.02% sodium azide and 50% glycerol pH 7.3.
-
Storage instructions
Store at -20℃. DO NOT ALIQUOT
-
Applications
Recommended Dilution:
WB: 1:500-1:5000
IHC: 1:20-1:200
IF: 1:10-1:100
-
Validations

HeLa cells were subjected to SDS PAGE followed by western blot with Catalog No:109087(SLC3A2 antibody) at dilution of 1:500

Immunohistochemical of paraffin-embedded human testis using Catalog No:109087(SLC3A2 antibody) at dilution of 1:100 (under 40x lens)
Immunohistochemical of paraffin-embedded human testis using Catalog No:109087(SLC3A2 antibody) at dilution of 1:100 (under 10x lens)

Immunofluorescent analysis of HepG2 cells, using SLC3A2 antibody Catalog No:109087 at 1:25 dilution and Rhodamine-labeled goat anti-rabbit IgG (red). Blue pseudocolor = DAPI (fluorescent DNA dye).

1X10^6 HepG2 cells were stained with .2ug SLC3A2 antibody (Catalog No:109087, red) and control antibody (blue). Fixed with 90% MeOH blocked with 3% BSA (30 min). Alexa Fluor 488-congugated AffiniPure Goat Anti-Rabbit IgG(H+L) with dilution 1:1000.
-
Background
CD98 is a cell-surface heterodimer consisting of a heavy chain (CD98hc) and a light chain. CD98hc also interacts with certain integrin b-subunits to regulate cell migration, survival, proliferation, and adhesion/polarity. CD98hc is overexpressed on the cell surface of many cancers and increased CD98hc expression is associated with the development and progression of tumors.(PMID:25084765). This protein has 4 isoforms produced by alternative splicing.
-
References
- Fei F, Li X, Xu L. CD147-CD98hc complex contributes to poor prognosis of non-small cell lung cancer patients through promoting cell proliferation via the PI3K/Akt signaling pathway. Annals of surgical oncology. 21(13):4359-68. 2014.
- Ke X, Chen Y, Wang P, Xing J, Chen Z. Upregulation of CD147 protects hepatocellular carcinoma cell from apoptosis through glycolytic switch via HIF-1 and MCT-4 under hypoxia. Hepatology international. 8(3):405-14. 2014.
Related Products / Services
Please note: All products are "FOR RESEARCH USE ONLY AND ARE NOT INTENDED FOR DIAGNOSTIC OR THERAPEUTIC USE"
